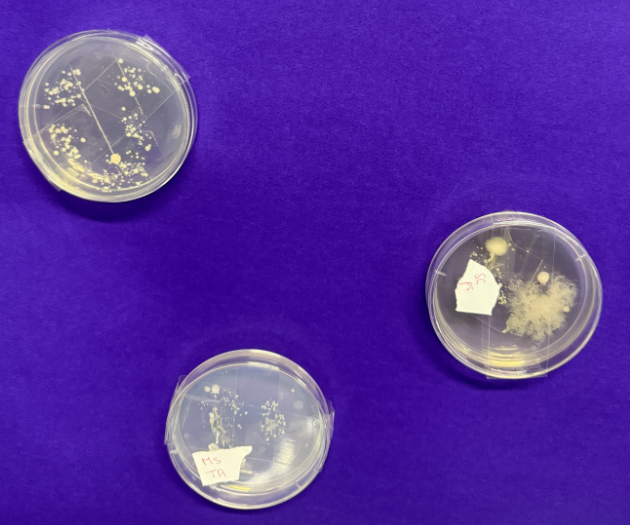

Gallery
Welcome to Year 6's gallery.
2025 - 2026
Throughout the year we will add photographs and videos of all the amazing learning we do.
Our Spring Enquiry: "Does your circumstance determine your destiny?"
As artists, we were influenced by William Morris and his block painting.





Take a listen to our Highwayman Part 2 narrative poems!











WORLD BOOK DAY 2026












We became taxonomists and classified our own creatures into different animal classification groups. We know that some animals, like the platypus, may have different characteristics.
We then used AI to make them come to life!






As scientists, we classified animals into different taxonomy groups. Also, we put our fingers into petri dishes to see what bacteria on our skin! We are looking forward to watching it grow as part of our investigations.

As scientists, we tested the effect volts and different components would have on the brightness of a light bulb. We now understand voltage is the force that keeps the current flowing around a circuit. Single cells are worth 1.5V!



During aspiration day, we share our dreams and future careers. We create vision moods stating the steps we must follow to get there. From pilots to teachers, footballers to government officials – we know if we work hard, the world is our oyster.



As musicians, we have listened to lots of different genres, including rock 'n' roll! We have mastered playing and singing in harmony! We gave our opinions and analysed the use of instruments to share emotions too.

We are ready for our SPRING ENQUIRY! Term one, done.
Our conclusion to our Autumn enquiry question: Does economy reflect success?

As part of our enquiry, we have designed and sewn our own interpretation of Kente Cloth, as design technicians.

![]()

















In English we have written explanation texts on Fair Trade. Have a read of them below:







As scientists, we investigated refraction. We observed what happens when light travels through the air and into water.


We're all ready the new academic year and our first enquiry is: Does an economy reflect success?
We're all ready for the summer term and our new enquiry: Are we a product of our heritage?
In English we wrote Part 2 of The Highwayman - have a listen to some of our narrative poems
In English we wrote Part II of The Highwayman - have a read of our fantastic narrative poems
For World Book Day we followed a drawing lesson with the illustrator Rob Biddulph. Have a look at some of our creations. We also had some great entries to our Book in a Box competition.
As part of our enquiry, we looked at the work of William Morris and designed our own wallpaper influenced by his work. Have a look at the printing in progress.
As part of this term's science learning, we are growing our own mould.
We have created double page spreads to capture this term's learning in RE.
We had a great time at the Valentine's disco.
As part of our enquiry, we experienced what life was like for children at school in Victorian times. We had lessons on the 3 rs (reading, writing and arithmetic) recited the Lord's Prayer and took part in drill. Some children even had to wear the dunces hat!
We were visited by the NHS so we could learn about the importance of sleep. Our visitors explained that we should be aiming for around 9-12 hours sleep each night in order to maintain good health and regulate our emotions, to grow, and to improve our memories.

As part of our enquiry we have learned about the different Acts that were introduced during the Victorian era to make life better for children. Have a listen to what we found out.
As part of Safer Internet Day we learned about scams and created fact files on how to spot a scam.
As part of our learning in science, we planned and carried out an investigation to find out how components in a circuit affect the brightness of a bulb
As part of our hook into our new unit of writing, in groups we performed part of the play Oliver
As part of our history enquiry we have looked at the similarities and differences between the rich and poor children living in Victorian times. Have a listen to what we found out.
All ready for the Spring term's enquiry - Does your circumstance determine your destiny?
Celebrating our Autumn term's enquiry!
As part of our enquiry we looked at the work of M.C. Escher, learning about depth and distortion and produced our own sketches influenced by his work: The Hand Reflecting Globe to show what success means to us. Have a look at our fabulous work.
As part of our learning in science, we have had a visit from Leon's Legacy where we dissected hearts!
As part of our enquiry we have designed our own Kente cloth and created it through using a running stitch and back stitch
In English we have written diary entries based on a day in the life of a Kaya girl. Have a listen to them below.
We've had a visit from the fire service to learn about the dangers of fire and how to keep safe. We were given a safety plan to take home to make sure we're safe in the home.

As part of our enquiry, we have been practising our sewing skills in preparation for making our own Kente cloth.
Look at our budding scientists as part of World Science Day - we learned how to make invisible ink!
As part of our PSHE learning, the PSCOs came in to talk to us about keeping safe at Halloween and Bonfire Night.

We had some amazing costumes at the Halloween disco
In English we have written explanations on Fair Trade linked to our enquiry. Have a read of our fantastic work.
In PE we have been learning to transfer matching sequences in unison and using a canon.
In science we have been learning about light and investigated refraction, have a look at our results.
In English we have been writing our own Anansi folk tales. Have a listen to some of our stories.
As part of our enquiry we cooked a 3 course meal for our parents, Italian Bruschetta, Ghanaian Tomato Stew and Brazilian Brigadeiros
We had a great hook day, learning some African drumming then creating our own in groups.
We're all set for the Autumn term. Have a look at our fabulous corridor ready for our enquiry "Does an economy reflect success?".
As part of our enquiry, we created our own Pinxton Pottery inspired by Pinxton Porcelain.We had to show something that is important to our heritage. Have a look at some of our work.
In art, we used the discipline of interpretation to create observational drawings and comment on the Blue Willow pattern seen on Chinese pottery. We had some great interpretations, have a look below.
As part of our enquiry, we had a visit from local historian Norman to help us learn about the history and significance of Pinxton Porcelain.
In PSHE, Mrs Dobson from Derbyshire Road Safety came in to talk to use about safe journeys as we get ready to move to our secondary schools in September
To start our enquiry we explored portraits and different techniques such as shading and smudging using a range of pencils, chalks and charcoals
All ready for our summer term enquiry - Are we a product of our heritage?
Celebrating our Spring Term enquiry learning
We had some eggcellent decorated eggs for Easter.
Have a look at the fantastic creative homework as part of our enquiry.
In science we have been learning about microorganisms and classification. Have a look at our double page spreads showcasing all of our learning.
We came dressed as our favourite book character or in our pyjamas and some made a book in a box to celebrate world book day.
In art, as part of our enquiry, we explored and appreciated the work of William Morris and used his work to inspire our own designs to create our own wallpaper using block printing. We went through the whole process of designing, making our block prints and then printing in one day. Have a look at us in action and our finished pieces.
Have a listen to our Highwayman Part II poems - they really are fantastic.
In English, we have explored the narrative poem, The Highwayman part I and then wrote our own versions of part II. Have a look at some amazing narrative poems and the figurative language used.
As part of our enquiry, we researched the the different acts introduced in the Victorian era and presented our findings to the rest of the class. We had to find out when and why the acts were introduced and the impact these had. Scan the QR codes below to hear what we found out.
As part of Children's Mental Health Week, we learned that our voice matters. We then showed all the different things in our lives that matter to us.
As part of Safer Internet Day, we talked about our favourite things to do online and the many changes technology has seen over the years.

In PSHE, we've had a visit from our school nurse Anna to deliver a workshop all about the importance of sleep.
In science, we have been investigating the question, do the number of components effect the brightness of a bulb?
A great 3 sessions of bike ability, well done to everyone who took part and passed!
We've had a brilliant hook day experiencing a Victorian school to start our new enquiry
Our hook day, experiencing a Victorian school
Have a sneaky peak at our corridor ready for our spring enquiry - Does your circumstance determine your destiny?
Our corridor ready for Spring term
Celebrating our learning from our Autumn enquiry - Does an economy reflect success?
As part of our learning in science, Leon's Legacy came into school to dissect hearts with us. We had an amazing time learning about the different parts of the heart and what they actually look and feel like!
In art we have been developing our skills in perspective drawing with depth and distortion. We looked at the work of M.C. Escher and then created our own sketches inspired by his piece - The Hand with Reflecting Sphere. Have a look at our amazing work below.
In design and technology, as part of our enquiry, we have designed our own Kente cloth and are now creating it using our new found sewing skills
In English we have been writing diaries about the day in the life of a kayayoo girl / boy. Have a listen to some of the amazing extracts below
As part of our enquiry, we have been learning about the importance of Kente cloth, what different patterns and colours represent. We've used this knowledge to design our own Kente cloth, naming the pattern and reasons for the choices of colours. We've had some really great and thoughtful designs that will look amazing once made.
For World Science day we dressed up as scientists and learned about diffusion, carrying out the skittles experiment. Have a look at the amazing results!
We have written explanation texts on light. Have a look at some of the amazing writing we've produced.
In science we investigated how different coloured filters changed the colour of objects
As part of our enquiry, we researched the natural resources that Ghana and Brazil have and then presented our research to our classes. Scan the QR codes to hear what we found out.
Aspiration Day
Aspiration Day
Aspiration Day
Aspiration Day
Aspiration Day
Aspiration Day
In English we have written non-chronological reports about Ghana to link with our enquiry. Have a look at the fantastic writing we've produced.
What a busy day Year 6 have had. As part of our enquiry, we have cooked a 3 course meal for our parents to come in and try. Have a look at how busy we've been.
As part of our hook day for our enquiry - Does an economy reflect success? We watched and listened to some Ghanain drumming for a Kente festival. We then used our percussion instruments to compose our own African style rhythms and chants.
Year 6 had a visit from Derbyshire Fire Service to learn how to stay safe around fire, what the main causes of fire are in the home and the impact of arson and hoax calls. Everyone took home a fire safety plan to make sure they are safe at home. Thank you Adele.
Have a look at our corridor ready for our Autumn enquiry - Does an economy reflect success?
Year 6 took part in the NSPCC Speak out, Stay Safe workshop as a follow up to their online assembly. We learned the importance of telling a trusted adult if we are worried about something or to call Childline 0800 1111
